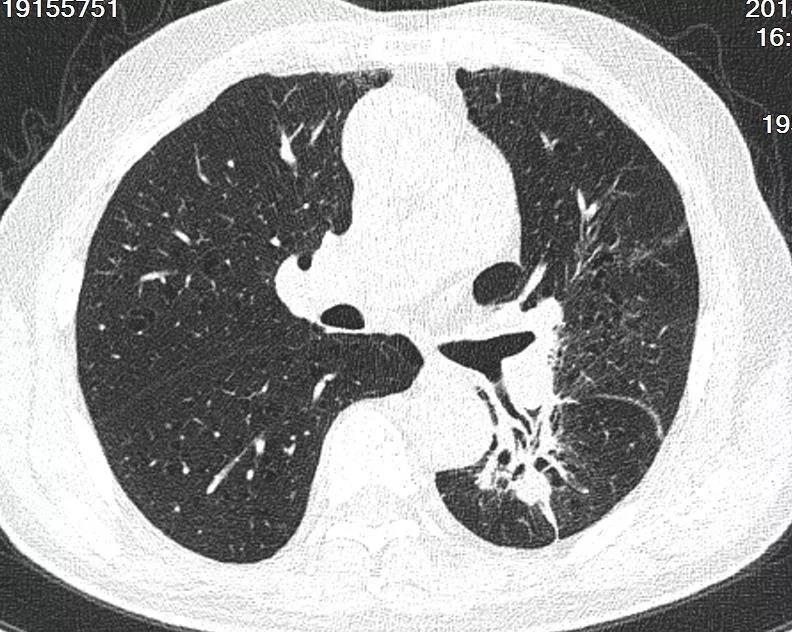

查看更多
密码过期或已经不安全,请修改密码
修改密码
壹生身份认证协议书
同意
拒绝
同意
拒绝
同意
不同意并跳过
罹患晚期肿瘤,失去手术机会,
难道就没有办法了吗?
采取姑息疗法呀!
姑息不是什么都不管,任由肿瘤疯长?
实际上,这是对姑息治疗的误解。肿瘤专家指出,姑息治疗也可以有所作为,不仅能够改善患者的生存质量,还有助于延长生存时间。个别情况下,甚至能创造生命的奇迹。
2018年12月21日,是65岁的周大爷复诊的日子,他的心情有点忐忑。

两个月前,他因难治性大咯血由外院转入泰州市人民医院呼吸与危重症医学科。

当时每天的出血量达200 ml,泰州市人民医院呼吸与危重症医学科副主任江爱桂医生,为他做了常规气管镜检查,镜下发现左肺中央型鳞癌骑跨于左主气管远段,左上叶及下叶支气管明显狭窄,左上叶不张。

支气管镜可见左肺中央型鳞癌骑跨于左主气管远段,左上叶及下叶支气管明显狭窄,左上叶不张。
考虑到患者活动性大咯血呈持续状态,江医生先行氩气刀烧灼止血,再通过支气管镜在其管腔内的肿瘤内植入20粒I125粒子,术后联合全身化疗。


粒子植入
如今,两个月过去了,也不知效果如何?
周大爷心里七上八下的,也属正常。


术后第二天胸部CT提示左肺门占位,左上肺不张,左肺门粒子植入术后
当复诊检查结果出来时,周大爷和江爱桂博士都显得异常激动,因为患者的支气管明显开通,左上肺复张,左肺实体病灶缩小50%。

术后联合化疗两月后复查胸部CT提示支气管明显开通,左上肺复张,左肺实体病灶缩小50%
江医生告诉小编,周大爷是他今年以来收治的第5例应用该技术的患者,病情控制的效果高于预期。
江医生介绍,经支气管镜近距离放疗治疗晚期中央型非小细胞肺癌(NSCLC)的临床研究,是呼吸与危重症医学科今年开展的一项临床新技术,该技术主要是支气管镜引导下,将发出低能量γ射线的I125粒子通过TBNA术直接植入肿瘤组织内或通过植入I125粒子支架,对肿瘤组织进行持续性的、最大限度地毁灭性杀伤。
该技术为中央型肺癌患者提供了一项新的有效的姑息治疗手段,可最大限度地永灭肿瘤细胞,最大限度地保留患者的肺功能,改善患者气管通畅程度,提高患者的生存质量。
经支气管镜近距离放疗治疗技术,主要适应以下状况:
恶性中心气道外压性狭窄
恶性中心气道内肿瘤
上腔静脉阻塞综合征
江医生介绍,晚期中央型NSCLC累及中心气道后往往会导致气道重度狭窄,病情凶险,临床风险极高,老年患者尤为明显,发现时往往失去手术及放化疗的机会,尽管靶向治疗药物副作用小,但仅适合部分有始动基因突变的非鳞癌患者。

经支气管镜I125粒子植入术或I125粒子支架治疗晚期中央型非小细胞肺癌,疗效确切,I125粒子能对肿瘤组织进行持续性的、最大限度地毁灭性杀伤,能为中央型肺癌患者提供了一项新的有效的姑息治疗手段,其技术特点与传统的呼吸内镜介入治疗,如高频电切除及支架植入技术优势互补,且能最大限度地保留患者的肺功能,改善患者气道通畅程度,提高患者的生存质量,且操作简单,创伤小,恢复快。

I125粒子植入治疗具有如下特点:
❆ I125粒子辐射直径仅1.7cm,能量绝大部分被组织吸收,无须特别的屏蔽防护;
❆ I125粒子植入对肿瘤组织直接照射,局部照射剂量远比正常组织高得多;能最大限度杀伤肿瘤细胞,对正常组织和敏感组织损伤小;
❆ 持续性、低剂量反复照射,对肿瘤组织的生物效应明显提高,对DNA双链破坏完全;
❆ 放射源始终存放在专用的容器内,操作过程中工作人员不直接接触粒子,操作安全,易于防护;
❆ I125粒子属于放射性药品,需要核医学科才能订购和专有的场所存放;I125粒子植入需要核医学科的合作才能共同完成。
江医生介绍,开展经支气管镜I125粒子植入术,具有较高的技术难度:一是需要熟练掌握支气管纵隔的解剖;二是需要熟练掌握TBNA穿刺技术。
但该技术的成功开展于切实解决本地区肺癌病患的看病难,方便本地区的群众就近治疗,减少治疗费用,降低患者转诊率,无疑是个利好的消息。
泰州市人民医院 平台发布
查看更多